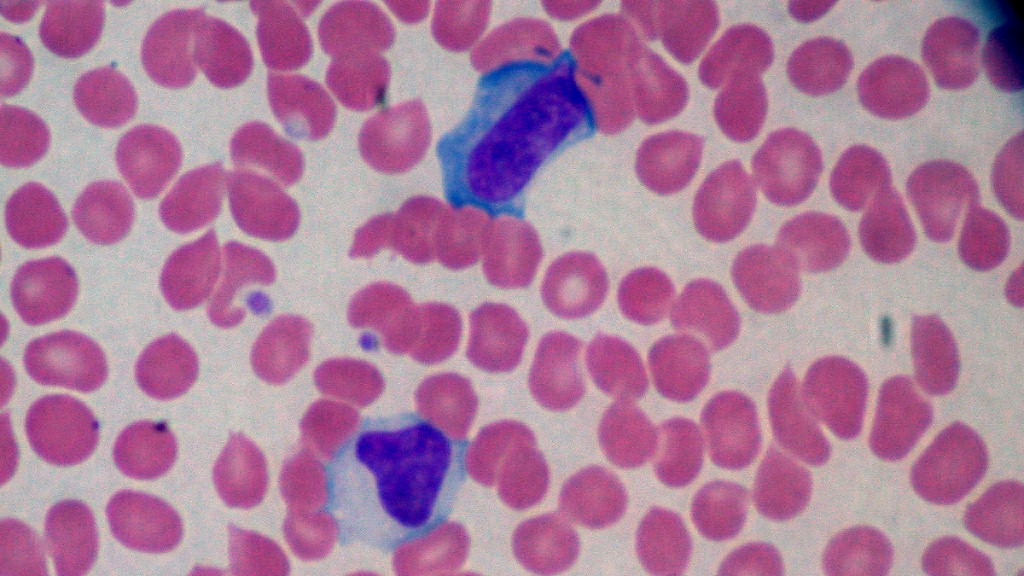
Esclerosis múltiple virus

La comunidad científica de Estados Unidos habría dado con el virus original que produce la esclerosis múltiple. Hicieron un experimento natural que duró aproximadamente 20 años con una gran muestra de soldados.
Ayer se anunció que gracias a un estudio hecho en Harvard con un seguimiento a 10 millones de estadounidenses, el virus que produciría el padecimiento es el de Epstein-Barr.
Este es a su vez el responsable detrás la enfermedad del beso, que adquirió conocimiento durante el último tiempo. Según señala el estudio, este virus puede multiplicar 32 veces la posibilidad de contraer EM.
¿Qué es la esclerosis múltiple?
Es una enfermedad en la que la mielina, membrana que recubre a las neuronas, se ve deteriorada. A su vez, existe una inflamación en los vasos sanguíneos del cerebro, lo que produce una reacción que repercute en todo el cuerpo.
Una persona con este padecimiento puede ver comprometida la visión, sensibilidad, movimiento, control de vejiga e intestinos y la coordinación.
Afecta más a mujeres que hombres
Muchas han sido las personas afectadas por este padecimiento sin cura. Incluso hay miembros de Hollywood que han tenido EM. Un caso conocido es el de Selma Blair.

La actriz de Crueles Intenciones, Hellboy, La Cosa Más Dulce entre otras grandes películas, fue diagnosticada con la enfermedad el 2018. Sin embargo, intenta salir adelante con el mayor optimismo posible.
Otra personalidad reconocible es Christina Applegate. La actriz fue diagnosticada el año pasado, y forma parte de una lista de 2.8 millones de personas que actualmente padecen esclerosis múltiple.

El gran descubrimiento del virus que produce la esclerosis múltiple se debe tratar con cautela, ya que si bien es un paso gigante para alcanzar una cura, aún queda un camino extenso por recorrer. Lo que sí, permite entender muchísimo mejor sobre cuáles son los riesgos del virus y lo vital que es evitar su contagio.
En Rock & Pop estamos siempre pendientes a los descubrimientos científicos, que día a día nos enseñan a vivir de mejor manera en un planeta que a ratos parece ser hostil.